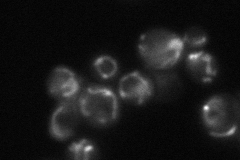
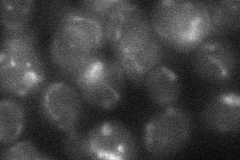
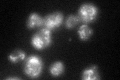

View description
Essential component of the Translocase of the Inner Mitochondrial membrane (TIM23 complex); involved in protein import into mitochondrial matrix and inner membrane; with Tim17p, contributes to architecture and function of the import channel
Localization:
Intensity:
Fold change:
Significance:
-
C’ GFP library in SD

mitochondria53.01 -
N' NOP1pr-GFP in SD

mitochondria98.6286 -
N' TEF2pr-mCherry in SD

mitochondria93.0315 -
N' NATIVEpr-GFP in SD
mitochondria58.4449 -
N' TEF2pr-VC and Cyto-VN in SD
mitochondria27.8617 -
C’ GFP library in SD+DTT
mitochondria44.460.83No -
C’ GFP library in SD+H2O2

mitochondria46.650.87No -
C’ GFP library in Starvation Media

mitochondria34.540.65No -
C’ GFP library on the background of Pup2-DaMP

mitochondria -
C’ GFP library on the background of CCT mutant

mitochondria51.2150.965965No
